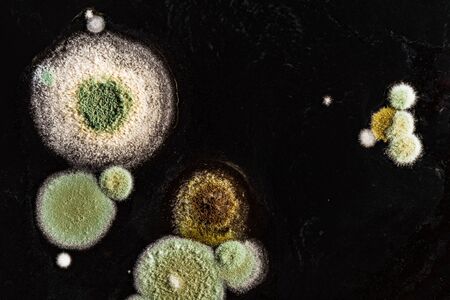
green yellow round fungal mold on a heterogeneous black surface, macro science abstract backgroundの写真素材

写真素材 - green yellow round fungal mold on a heterogeneous black surface, macro science abstract background
作品情報
green yellow round fungal mold on a heterogeneous black surface, macro science abstract background
- ID:98542248
- 作品種別:写真
- 作者名:Aliaksei Marozau
キーワード
- allergy
- antibiotic
- backdrop
- bad
- biochemistry
- biological
- biology
- closeup
- contaminated
- danger
- disease
- education
- food
- fungal
- fungi
- fungus
- germ
- green
- growth
- health
- illness
- infected
- infection
- medical
- micro
- microbe
- microbiology
- microscopic
- mildew
- mold
- mould
- mycelium
- nature
- organic
- penicillin
- petri
- proliferation
- replication
- reproduction
- rotten
- round
- science
- scientific
- spoiled
- spore
- spread
- structure
- texture
- unhealthy
- unhygienic
類似作品
Mold in food. G...
mold in orange ...
green yellow ro...
Moldy moldy mol...
A close up of a...
Yellow cups of ...
Mold covers the...
A vibrant clust...
Yellow and gree...
Xanthoria polyc...
A close up of a...
bright yellow l...
yellow and whit...
Spoiled lemon o...
Closeup of Mold...
macro image cap...
Mold closeup. M...
spread of green...
Single whole ye...
Blurred backgro...
Macro green org...
Very small fung...
green algae pon...
Colorful lichen...
Detail to micro...
Vibrant orange ...
mold on juice, ...
Yellow golf bal...
Very small fung...
rotten lemon, c...
Moss and lichen...
Stunning close-...
detail shot sho...
Mold. Nice mold...
Branches of a t...
Fungi colonies ...
Old Green Fungu...
A vibrant and c...
Generative AI :...
Colorful microo...
This macro phot...
Penicillium, as...
Mold in food. G...
Penicillium, as...
Backgrounds of ...
A close-up of l...
Macro photograp...
Backgrounds of ...
Green mold on f...